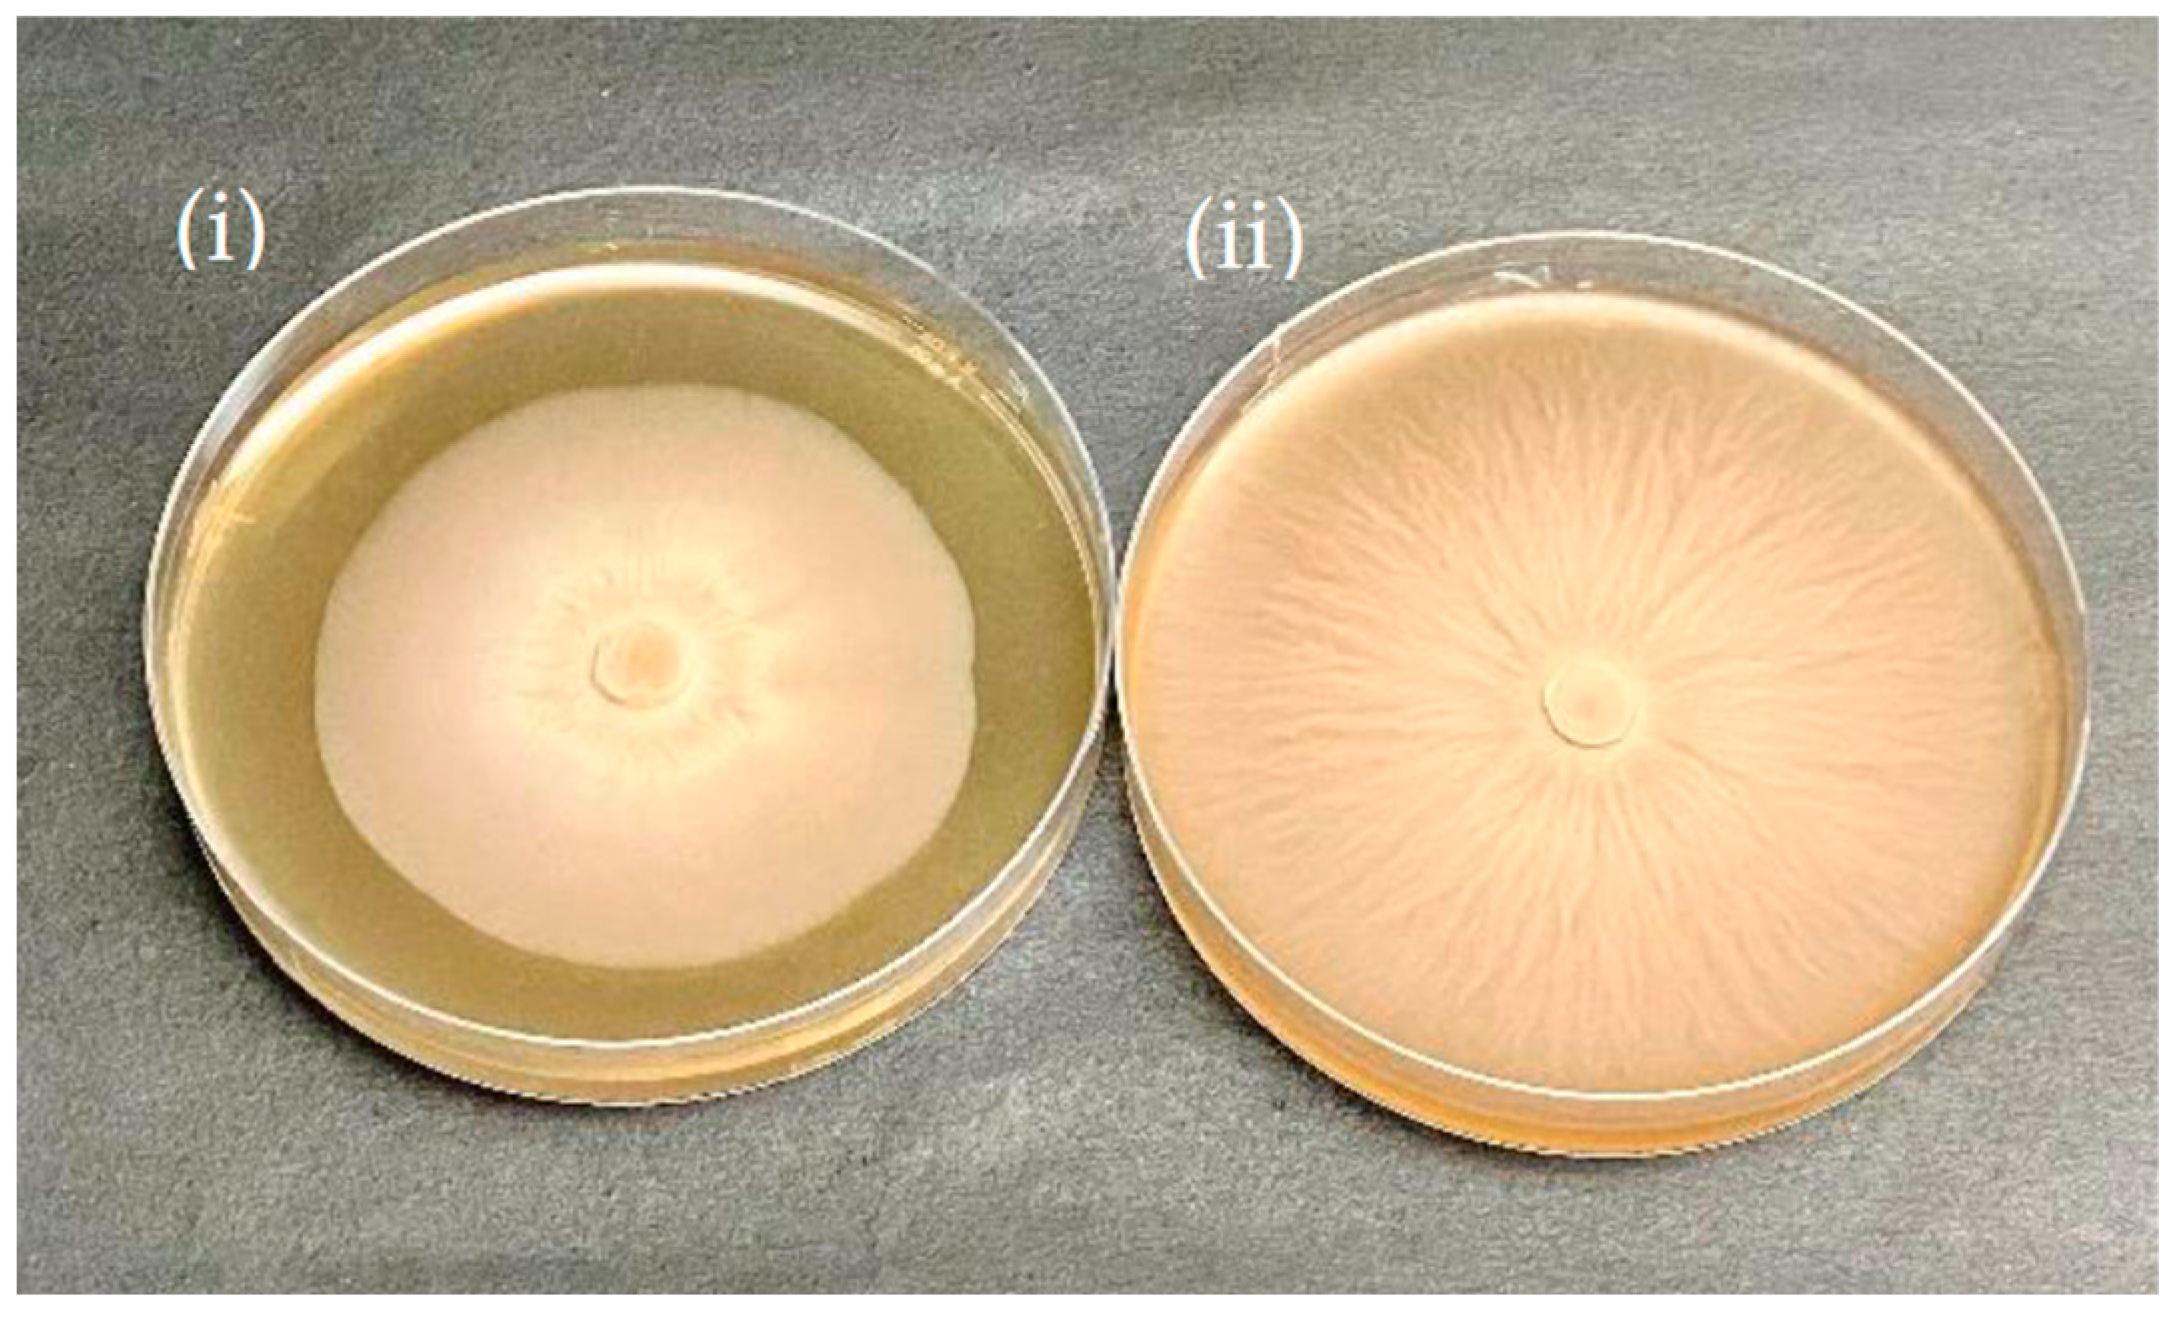
Jof 09 00260 g006 Jof 09 00260 g006

Co-Application of Silver Nanoparticles and Symbiotic Fungus Piriformospora indica Improves Secondary Metabolite Production in Black Rice
Abstract
1. Introduction
2. Methods
2.1. Materials and Reagents
2.2. Synthesis and Characterization of AgNPs
2.3. Fungus Piriformospora indica Culture Conditions
2.4. Black Rice Growth Conditions
2.5. Secondary Metabolite Analysis
2.5.1. Carotenoids
2.5.2. Chlorophyll
2.5.3. Saffrole
2.5.4. Flavonoids and Terpenoids
2.6. Statistical Analysis
3. Results
3.1. Characterizations of Silver Nanoparticles
3.2. Effects of Silver Nanoparticles on the Growth of P. indica
3.3. Microscopy Studies
3.4. Secondary Metabolite Analysis in Black Rice Leaves
4. Discussion
5. Conclusions
Author Contributions
Funding
Institutional Review Board Statement
Informed Consent Statement
Data Availability Statement
Acknowledgments
Conflicts of Interest
References
- Dhiman, T.K.; Lakshmi, G.; Dave, K.; Roychoudhury, A.; Dalal, N.; Jha, S.K.; Kumar, A.; Han, K.-H.; Solanki, P.R. Rapid and label-free electrochemical detection of fumonisin-b1 using microfluidic biosensing platform based on Ag-CeO2 nanocomposite. J. Electrochem. Soc. 2021, 168, 077510. [Google Scholar] [CrossRef]
- Dhiman, T.K.; Lakshmi, G.; Roychoudhury, A.; Jha, S.K.; Solanki, P.R. Ceria-nanoparticles-based microfluidic nanobiochip electrochemical sensor for the detection of ochratoxin-A. ChemistrySelect 2019, 4, 4867–4873. [Google Scholar] [CrossRef]
- Garimella, L.B.; Dhiman, T.K.; Kumar, R.; Singh, A.K.; Solanki, P.R. One-step synthesized ZnO np-based optical sensors for detection of aldicarb via a photoinduced electron transfer route. ACS Omega 2020, 5, 2552–2560. [Google Scholar] [CrossRef] [PubMed]
- Salama, H.M. Effects of silver nanoparticles in some crop plants, common bean (Phaseolus vulgaris L.) and corn (Zea mays L.). Int. Res. J. Biotechnol. 2012, 3, 190–197. [Google Scholar]
- Dalal, N. Microfluidic based electrochemical detection of fumonisin-b1 using silver-ceria nanocomposite. SPAST Abstr. 2021, 1. Available online: https://spast.org/techrep/article/view/1387 (accessed on 30 November 2022).
- Lakshmi, G.; Poddar, M.; Dhiman, T.K.; Singh, A.K.; Solanki, P.R. Gold-ceria nanocomposite based highly sensitive and selective aptasensing platform for the detection of the chlorpyrifos in Solanum tuberosum. Colloids Surf. A Physicochem. Eng. Asp. 2022, 653, 129819. [Google Scholar] [CrossRef]
- Singh, A.K.; Ahlawat, A.; Dhiman, T.K.; Lakshmi, G.; Solanki, P.R. Degradation of methyl parathion using manganese oxide (MnO2) nanoparticles through photocatalysis. SPAST Abstr. 2021, 1. Available online: https://spast.org/techrep/article/view/1027 (accessed on 30 November 2022).
- Dhoke, S.K.; Mahajan, P.; Kamble, R.; Khanna, A. Effect of nanoparticles suspension on the growth of mung (Vigna radiata) seedlings by foliar spray method. Nanotechnol. Dev. 2013, 3, e1. [Google Scholar] [CrossRef]
- Rane, M.; Bawskar, M.; Rathod, D.; Nagaonkar, D.; Rai, M. Influence of calcium phosphate nanoparticles, Piriformospora indica and Glomus mosseae on growth of Zea mays. Adv. Nat. Sci. Nanosci. Nanotechnol. 2015, 6, 045014. [Google Scholar] [CrossRef]
- Yang, R.Y.; Chang, L.C.; Hsu, J.C.; Weng, B.B.; Palada, M.C.; Chadha, M.L.; Levasseur, V. Nutritional and functional properties of Moringa leaves—From germplasm, to plant, to food, to health. In Proceedings of the Moringa and Other Highly Nutritious Plant Resources: Strategies, Standards and Markets for a Better Impact on Nutrition in Africa, Accra, Ghana, 16–18 November 2006; pp. 1–9. [Google Scholar]
- Zheng, L.; Hong, F.; Lu, S.; Liu, C. Effect of nano-TiO2 on strength of naturally aged seeds and growth of spinach. Biol. Trace Elem. Res. 2005, 104, 83–91. [Google Scholar] [CrossRef]
- Sharma, R.; Patel, S.; Pargaien, K.C. Synthesis, characterization and properties of Mn-doped ZnO nanocrystals. Adv. Nat. Sci. Nanosci. Nanotechnol. 2012, 3, 035005. [Google Scholar] [CrossRef]
- Sheykhbaglou, R.; Sedghi, M.; Shishevan, M.T.; Sharifi, R.S. Effects of nano-iron oxide particles on agronomic traits of soybean. Not. Sci. Biol. 2010, 2, 112–113. [Google Scholar] [CrossRef]
- Dawadi, S.; Katuwal, S.; Gupta, A.; Lamichhane, U.; Thapa, R.; Jaisi, S.; Lamichhane, G.; Bhattarai, D.P.; Parajuli, N. Current research on silver nanoparticles: Synthesis, characterization, and applications. J. Nanomater. 2021, 2021, 6687290. [Google Scholar] [CrossRef]
- Verma, A.K.; Mishra, A.; Dhiman, T.K.; Sardar, M.; Solanki, P. Experimental and in silico interaction studies of alpha amylase-silver nanoparticle: A nano-bio-conjugate. bioRxiv 2022. [Google Scholar] [CrossRef]
- Verma, D.; Dhiman, T.K.; Mukherjee, M.D.; Solanki, P.R. Electrophoretically deposited green synthesized silver nanoparticles anchored in reduced graphene oxide composite based electrochemical sensor for detection of bisphenol A. J. Electrochem. Soc. 2021, 168, 097504. [Google Scholar] [CrossRef]
- Verma, D.; Dhiman, T.K.; Mukherjee, M.D.; Solanki, P.R. The development of green synthesized AgNps anchored RGO nanocomposite based amperometric sensor for BPA detection. SPAST Abstr. 2021, 1. Available online: https://spast.org/techrep/article/view/180 (accessed on 30 November 2022).
- Mahajan, S.; Barthwal, S.; Attri, M.K.; Bajpai, S.; Dabral, S.; Khanuja, M.; Varma, A. Impact of ZnO nano materials on medicinal black rice seed germination. J. Miner. Mater. Charact. Eng. 2019, 7, 180. [Google Scholar] [CrossRef]
- Gill, S.S.; Gill, R.; Trivedi, D.K.; Anjum, N.A.; Sharma, K.K.; Ansari, M.W.; Ansari, A.A.; Johri, A.K.; Prasad, R.; Pereira, E.; et al. Piriformospora indica: Potential and significance in plant stress tolerance. Front. Microbiol. 2016, 7, 332. [Google Scholar] [CrossRef]
- Prasad, R.; Swamy, V.S. Antibacterial activity of silver nanoparticles synthesized by bark extract of Syzygium cumini. J. Nanopart. 2013, 2013, 431218. [Google Scholar] [CrossRef]
- Dabral, S.; Yashaswee; Varma, A.; Choudhary, D.K.; Bahuguna, R.N.; Nath, M. Biopriming with Piriformospora indica ameliorates cadmium stress in rice by lowering oxidative stress and cell death in root cells. Ecotoxicol. Environ. Saf. 2019, 186, 109741. [Google Scholar] [CrossRef]
- Rowndel, K.; Chongtham, S.; Bhupenchandra, I.; Singh, T.B.; Choudhary, S. Nutritional advantage of black rice—A heirloom rice. Indian Farming 2020, 69. Available online: https://epubs.icar.org.in/index.php/IndFarm/article/view/96997 (accessed on 30 November 2022).
- Wang, W.; Li, Y.; Dang, P.; Zhao, S.; Lai, D.; Zhou, L. Rice secondary metabolites: Structures, roles, biosynthesis, and metabolic regulation. Molecules 2018, 23, 3098. [Google Scholar] [CrossRef] [PubMed]
- Pereira-Caro, G.; Cros, G.; Yokota, T.; Crozier, A. Phytochemical profiles of black, red, brown, and white rice from the camargue region of france. J. Agric. Food Chem. 2013, 61, 7976–7986. [Google Scholar] [CrossRef] [PubMed]
- Pratiwi, R.; Purwestri, Y.A. Black rice as a functional food in Indonesia. Funct. Foods Health Dis. 2017, 7, 182–194. [Google Scholar] [CrossRef]
- Verma, S.; Varma, A.; Rexer, K.H.; Hassel, A.; Kost, G.; Sarbhoy, A.; Bisen, P.; Bütehorn, B.; Franken, P. Piriformospora indica, gen. et sp. nov., a new root-colonizing fungus. Mycologia 1998, 90, 896–903. [Google Scholar] [CrossRef]
- Attri, M.K.; Varma, A. Comparative study of growth of Piriformospora indica by using different sources of jaggery. J. Pure Appl. Microbiol. 2018, 12, 933–942. [Google Scholar] [CrossRef]
- Mirzaei, H.; Darroudi, M. Zinc oxide nanoparticles: Biological synthesis and biomedical applications. Ceram. Int. 2017, 43, 907–914. [Google Scholar] [CrossRef]
- Hilbert, M.; Novero, M.; Rovenich, H.; Mari, S.; Grimm, C.; Bonfante, P.; Zuccaro, A. Mlo differentially regulates barley root colonization by beneficial endophytic and mycorrhizal fungi. Front. Plant Sci. 2020, 10, 1678. [Google Scholar] [CrossRef]
- Saini, R.K.; Nile, S.H.; Park, S.W. Carotenoids from fruits and vegetables: Chemistry, analysis, occurrence, bioavailability and biological activities. Food Res. Int. 2015, 76, 735–750. [Google Scholar] [CrossRef]
- Hornero-Méndez, D.; Gandul-Rojas, B.; Mínguez-Mosquera, M.I. Routine and sensitive SPE-HPLC method for quantitative determination of pheophytin A and pyropheophytin A in olive oils. Food Res. Int. 2005, 38, 1067–1072. [Google Scholar] [CrossRef]
- Jiménez-Durán, A.; Barrera-Cortés, J.; Lina-García, L.P.; Santillan, R.; Soto-Hernández, R.M.; Ramos-Valdivia, A.C.; Ponce-Noyola, T.; Ríos-Leal, E. Biological activity of phytochemicals from agricultural wastes and weeds on Spodoptera frugiperda (je Smith) (Lepidoptera: Noctuidae). Sustainability 2021, 13, 13896. [Google Scholar] [CrossRef]
- Giese, M.W.; Lewis, M.A.; Giese, L.; Smith, K.M. Method for the analysis of cannabinoids and terpenes in cannabis. J. AOAC Int. 2015, 98, 1503–1522. [Google Scholar] [CrossRef] [PubMed]
- Kowalska, M.; Woźniak, M.; Kijek, M.; Mitrosz, P.; Szakiel, J.; Turek, P. Management of validation of HPLC method for determination of acetylsalicylic acid impurities in a new pharmaceutical product. Sci. Rep. 2022, 12, 1. [Google Scholar] [CrossRef] [PubMed]
- Kumar, M.; Devi, P.; Kumar, A. Structural analysis of PVP capped silver nanoparticles synthesized at room temperature for optical, electrical and gas sensing properties. J. Mater. Sci. Mater. Electron. 2017, 28, 5014–5020. [Google Scholar] [CrossRef]
- Singhal, U.; Khanuja, M.; Prasad, R.; Varma, A. Impact of synergistic association of ZnO-nanorods and symbiotic fungus Piriformospora indica DSM 11827 on Brassica oleracea var. Botrytis (broccoli). Front. Microbiol. 2017, 8, 1909. [Google Scholar] [CrossRef]
- Ichikawa, H.; Ichiyanagi, T.; Xu, B.; Yoshii, Y.; Nakajima, M.; Konishi, T. Antioxidant activity of anthocyanin extract from purple black rice. J. Med. Food 2001, 4, 211–218. [Google Scholar] [CrossRef]
- Mishra, P.K.; Mishra, H.; Ekielski, A.; Talegaonkar, S.; Vaidya, B. Zinc oxide nanoparticles: A promising nanomaterial for biomedical applications. Drug Discov. Today 2017, 22, 1825–1834. [Google Scholar] [CrossRef]
- Taghinasab, M.; Jabaji, S. Cannabis microbiome and the role of endophytes in modulating the production of secondary metabolites: An overview. Microorganisms 2020, 8, 355. [Google Scholar] [CrossRef]
- Wang, Y.; Dai, C.-C. Endophytes: A potential resource for biosynthesis, biotransformation, and biodegradation. Ann. Microbiol. 2011, 61, 207–215. [Google Scholar] [CrossRef]
- Vogt, T. Phenylpropanoid biosynthesis. Mol. Plant 2010, 3, 2–20. [Google Scholar] [CrossRef]
- Khare, E.; Mishra, J.; Arora, N.K. Multifaceted interactions between endophytes and plant: Developments and prospects. Front. Microbiol. 2018, 9, 2732. [Google Scholar] [CrossRef] [PubMed]
- Li, X.; Liu, Y.; Yu, Y.; Chen, W.; Liu, Y.; Yu, H. Nanoformulations of quercetin and cellulose nanofibers as healthcare supplements with sustained antioxidant activity. Carbohydr. Polym. 2019, 207, 160–168. [Google Scholar] [CrossRef] [PubMed]
- Mohanlal, S.; Parvathy, R.; Shalini, V.; Mohanan, R.; Helen, A.; Jayalekshmy, A. Chemical indices, antioxidant activity and anti-inflammatory effect of extracts of the medicinal rice “njavara” and staple varieties: A comparative study. J. Food Biochem. 2013, 37, 369–380. [Google Scholar] [CrossRef]
- Khan, T.; Khan, M.A.; Karam, K.; Ullah, N.; Mashwani, Z.-u.-R.; Nadhman, A. Plant in vitro culture technologies; a promise into factories of secondary metabolites against COVID-19. Front. Plant Sci. 2021, 12, 610194. [Google Scholar] [CrossRef]
- Mohd-Hairul, A.; Namasivayam, P.; Cheng Lian, G.E.; Abdullah, J.O. Terpenoid, benzenoid, and phenylpropanoid compounds in the floral scent of Vanda mimi palmer. J. Plant Biol. 2010, 53, 358–366. [Google Scholar] [CrossRef]

| Compound | Control (µg/g) | AgNPs (µg/g) | Piriformospora indica (µg/g) | NEF (µg/g) |
|---|---|---|---|---|
| Chlorophyll (a + b) | 2928.33 ± 33.93 d | 3637.73 ± 42.15 c | 4632.38 ± 53.68 b | 5852.61 ± 67.82 a |
| Carotenoid | ||||
| Alpha Carotenoid | 54.07 ± 0.62 d | 71.25 ± 0.82 c | 90.31 ± 1.04 b | 118.35 ± 1.36 a |
| Beta Carotenoid | 203.71 ± 2.36 d | 267.29 ± 3.09 c | 343.96 ± 3.98 b | 455.69 ± 5.28 a |
| Safrole | nd | nd | Nd | nd |
| Flavonoids | ||||
| Quercetin | 177.85 ± 2.05 d | 234.77 ± 2.72 c | 297 ± 3.44 b | 421.75 ± 4.88 a |
| Apigenin | 237.58 ± 2.75 d | 313.60 ± 3.63 c | 397.77 ± 4.61 b | 564.84 ± 6.54 a |
| Myricetin | 199.51 ± 2.31 d | 262.35 ± 3.04 c | 334.18 ± 3.87 b | 474.55 ± 5.5 a |
| Catechin | 208.53 ± 2.4 d | 275.26 ± 3.16 c | 352.92 ± 4.09 b | 494.53 ± 5.69 a |
| Kaempferol | 138.17 ± 1.58 d | 187.34 ± 3.71 c | 235.86 ± 2.73 b | 339.46 ± 6.72 a |
| Isorhamnetin | 183.61 ± 3.63 d | 242.43 ± 4.8 c | 302.54 ± 3.5 b | 435.41 ± 8.62 a |
| Luteolin | 259.99 ± 5.14 d | 343.20 ± 6.79 c | 427.40 ± 4.95 b | 606.91 ± 7.03 a |
| Luteolin-7-0-glucosides | 71.56 ± 1.42 a | 83.52 ± 11.14 a | 71.48 ± 7.55 a | 76.48 ± 3.19 a |
| Apigenin-7-0-glucoside | 61.66 ± 0.57 a | 56.68 ± 0.60 b | 56.34 ± 1.06 b | 61.96 ± 2.70 a |
| Quercetin-3-0-rutinosides | 51.83 ± 1.03 a | 51.05 ± 0.94 a | 45.78 ± 0.22 b | 48.35 ± 0.75 b |
| Isorhamnetin-3-0-glucosides | 67.28 ± 0.75 a | 66.14 ± 1.08 a | 63.54 ± 1.60 a | 63.20 ± 2.46 a |
| Quercetin-3-0-glucosides | 73.61 ± 1.44 a | 63.49 ± 0.87 c | 67.77 ± 1.19 b | 66.72 ± 1.40 bc |
| Tricin | 1330.87 ± 26.35 d | 1757.78 ± 34.81 c | 2222.56 ± 44.01 b | 3156.05 ± 62.49 a |
| Tricin-4-0 erythro-B guaiacylglyceryl | 59.27 ± 0.87 b | 59.25 ± 1.11 b | 60.52 ± 1.63 b | 65.48 ± 1.42 a |
| Terpenoids | ||||
| Beta Cymene | 370.52 ± 7.33 d | 479.25 ± 1.03 c | 610.13 ± 1.00 b | 821.66 ± 16.27 a |
| Gamma-Terpinene | 99.21 ± 2 d | 130.99 ± 2.64 c | 173.48 ± 3.43 b | 229 ± 4.53 a |
| Terpinen-4-ol | 135.69 ± 2.68 d | 179.18 ± 3.55 c | 227.97 ± 4.51 b | 300.92 ± 5.96 a |
| Beta-Pinene | 47.97 ± 0.95 c | 64.25 ± 1.27 ab | 80.6 ± 1.59 ab | 139.68 ± 59.49 a |
| Alpha-Elemene | 121.56 ± 2.46 d | 160.39 ± 3.24 c | 209.75 ± 2.40 b | 281.63 ± 5.57 a |
| Linalool | 53.06 ± 1.05 d | 70.14 ± 1.39 c | 89.15 ± 1.76 b | 117.88 ± 2.33 a |
| 10-acetylmethyl-3-carene | 97.96 ± 1.94 d | 129.41 ± 2.56 c | 164.58 ± 3.26 b | 217.27 ± 4.30 a |
| Carveol | 13.74 ± 0.28 c | 15.73 ± 1.21 bc | 17.32 ± 1.14 b | 31.73 ± 0.63 a |
| Limonene | 308.74 ± 6.11 d | 407.79 ± 8.07 c | 518.8 ± 10.27 b | 684.66 ± 13.55 a |
| Caryophyllene | 70.41 ± 1.39 d | 93.37 ± 1.85 c | 118.3 ± 2.34 b | 156.17 ± 3.09 a |
| Sabinene | 70.23 ± 1.41 b | 68.03 ± 1.78 b | 70.68 ± 1.14 b | 157.32 ± 1.55 a |
| Beta-Ocimene | 202 ± 4 d | 266.91 ± 5.28 c | 339.46 ± 6.72 b | 447.97 ± 8.87 a |
| Trans-Linalool | 135.89 ± 2.69 d | 179.40 ± 3.55 c | 228.29 ± 4.52 b | 302.62 ± 5.99 a |
| Cis linalool | 59.81 ± 1.21 b | 69.91 ± 3.40 b | 66.24 ± 3.80 b | 134.99 ± 3.92 a |
| Myrcene | 198.95 ± 3.93 d | 232.06 ± 4.59 c | 334.24 ± 6.61 b | 442.60 ± 8.76 a |
Disclaimer/Publisher’s Note: The statements, opinions and data contained in all publications are solely those of the individual author(s) and contributor(s) and not of MDPI and/or the editor(s). MDPI and/or the editor(s) disclaim responsibility for any injury to people or property resulting from any ideas, methods, instructions or products referred to in the content. |
© 2023 by the authors. Licensee MDPI, Basel, Switzerland. This article is an open access article distributed under the terms and conditions of the Creative Commons Attribution (CC BY) license (https://creativecommons.org/licenses/by/4.0/).
Share and Cite
Solanki, S.; Lakshmi, G.B.V.S.; Dhiman, T.; Gupta, S.; Solanki, P.R.; Kapoor, R.; Varma, A. Co-Application of Silver Nanoparticles and Symbiotic Fungus Piriformospora indica Improves Secondary Metabolite Production in Black Rice. J. Fungi 2023, 9, 260. https://doi.org/10.3390/jof9020260
Solanki S, Lakshmi GBVS, Dhiman T, Gupta S, Solanki PR, Kapoor R, Varma A. Co-Application of Silver Nanoparticles and Symbiotic Fungus Piriformospora indica Improves Secondary Metabolite Production in Black Rice. Journal of Fungi. 2023; 9(2):260. https://doi.org/10.3390/jof9020260
Chicago/Turabian StyleSolanki, Shikha, G. B. V. S. Lakshmi, Tarun Dhiman, Samta Gupta, Pratima R. Solanki, Rupam Kapoor, and Ajit Varma. 2023. "Co-Application of Silver Nanoparticles and Symbiotic Fungus Piriformospora indica Improves Secondary Metabolite Production in Black Rice" Journal of Fungi 9, no. 2: 260. https://doi.org/10.3390/jof9020260
APA StyleSolanki, S., Lakshmi, G. B. V. S., Dhiman, T., Gupta, S., Solanki, P. R., Kapoor, R., & Varma, A. (2023). Co-Application of Silver Nanoparticles and Symbiotic Fungus Piriformospora indica Improves Secondary Metabolite Production in Black Rice. Journal of Fungi, 9(2), 260. https://doi.org/10.3390/jof9020260

